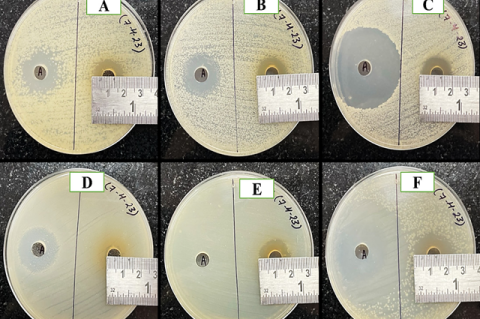

sys1
Latest posts from sys1
Latest
Unveiling Tigliane Derivatives as Novel Therapeutics for Alzheimer's Disease
3 hours 19 min ago [comment_count]
Read more
Evaluation of the Anthelmintic Potential of Pongamia pinnata Root Hydroalcoholic Extract against Tubifex tubifex
3 hours 23 min ago [comment_count]
Read morePhytochemical Screening and Anthelmintic Activity of Hydroalcoholic Extract of Leaves of Sphaeranthus indicus
3 hours 28 min ago [comment_count]
Read more
Acorus calamus Exhibiting Antidiabetic Activity: An in vitro and in silico Approach
3 hours 38 min ago [comment_count]
Read more
Tooth Resorption: A Comprehensive Review of Pathophysiology, Classification, Diagnosis and Management
3 hours 44 min ago [comment_count]
Read more
Antibacterial Properties of Cow Urine Collected from a Badri Calf
3 hours 52 min ago [comment_count]
Read more